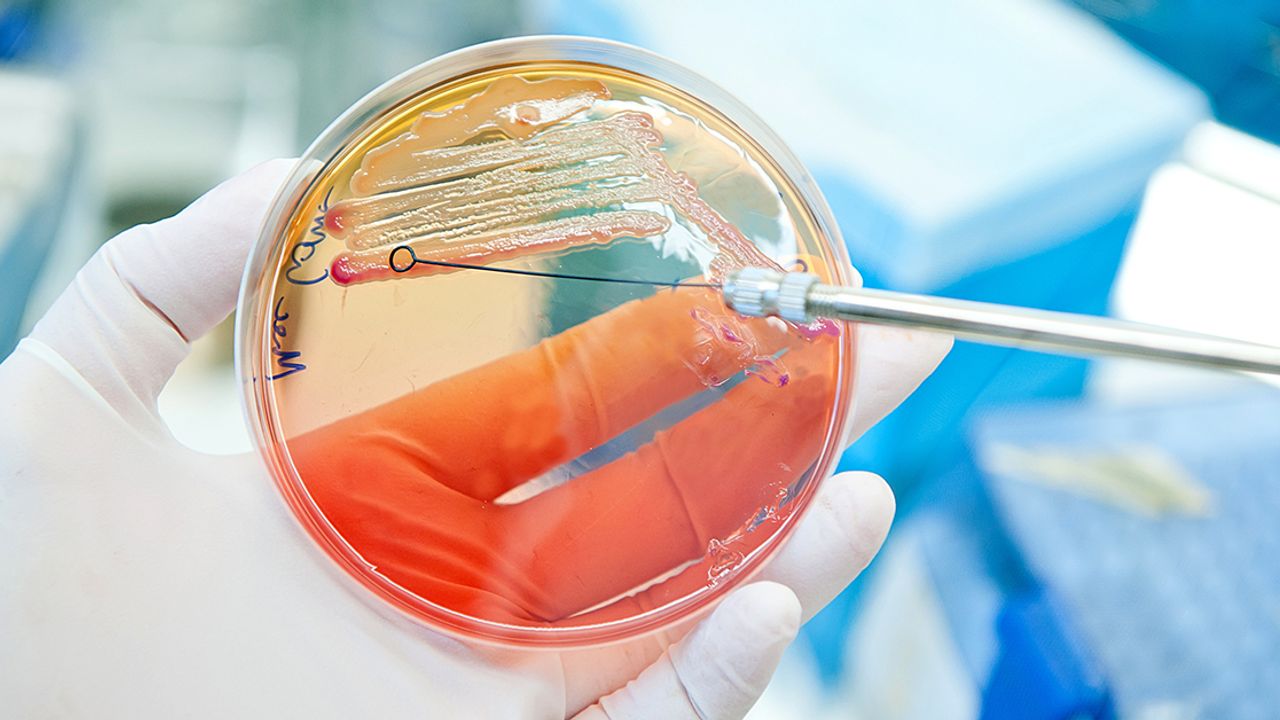

Almanya’da, E. Coli (STEC) bakterisi kaynaklı salgın nedeniyle bazı şirketler, ürünleri arasında yer alan peynir ve sosisleri marketlerden geri çağırdı.
Etablissements Dubois-Boulay firması, son kullanma tarihi 31 Ekim 2025 ve 15 Aralık 2025 olan "Chavignol Aop Dubois Boulay" markalı peynirini raflardan geri çekti.
Aynı şirket iki hafta önce Crottin de Chavignol markalı çiğ sütten yapılmış keçi peynirini yine aynı sebepten geri çağırmıştı.
Öte yandan Radeberger et ürünleri firması da E.Coli bakterisi nedeniyle son kullanma tarihi 4 Kasım 2025 olan "Orijinal Radeberger Rindfleischknacker" sosis ürününü geri çağırdığını duyurdu.
Sosisin tüketilmemesi ve iade edilerek parasının alınması tavsiye edildi.
Geri çağrılan et ve süt ürünlerini daha önce satın alanlara, ürünleri tüketmemişlerse çöpe atmaları veya iade etmeleri, tüketmişlerse sağlık durumlarını yakından izlemeleri tavsiye edildi.
E. Coli enfeksiyonunda, özellikle bebekler, küçük çocuklar, yaşlılar ve bağışıklık sistemi zayıf kişiler, daha ciddi hastalıklar geliştirme riski altında bulunuyor.
Robert Koch Enstitüsünün (RKI) dün yayımladığı rapora göre, bir erkek çocuk ile bir kadının E.Coli salgını nedeniyle öldüğü ifade edilmişti.
Söz konusu iki kişinin, E. Coli bakterisine bağlı böbrek yetmezliği nedeniyle hayatını kaybettiği bildirilmişti.